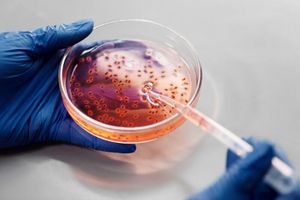

Înainte de a citi acest articol, vă invităm să citiți partea I, care poate fi găsită aici.
Situația cu măștile se poate întâmpla și în domeniul ADN-ului. BGI are tehnologia, capacitatea, fondurile și experiența necesare, în timp ce-și extinde influența rapid la nivel global. Conform website-ului companiei, BGI își desfășoară afacerile în peste 100 de țări și are 11 centre și laboratoare în SUA. BGI „a încheiat numeroase parteneriate cu furnizori de servicii medicale și organizații care se ocupă de cercetare în SUA, pentru a oferi servicii de secvențiere pe scară largă, în vederea susținerii eforturile de cercetare din domeniul medical,” conform unui raport din 2019 al Comisiei de Revizuire Economică și Securitate SUA-China (USCC).
În aparență, BGI vede COVID-19 ca fiind oportunitatea perfectă pentru a-și adânci impactul pe care-l are în Statele Unite. Într-o scrisoare către guvernatorul Washington, Jay Inslee, Wang a menționat că BGI deja a donat produse către Universitatea Washington și s-a oferit să doneze mai mult „imediat ce produsul nostru primește aprobările necesare.” Acest lucru sugerează că BGI speră ca în urma favorului pe care-l face, să obțină aprobările mai repede și mai ușor, sau să le fie oferit un avantaj competitiv într-un fel anume.
BGI reprezintă o amenințare mai mare pentru că nu doar vinde produse, dar de asemenea colectează datele noastre personale care ne fac unici in lume: ADN-ul. Multe persoane din industria de biotehnologie și din cadrul mai multor guverne și-au exprimat îngrijorarea în legătura cu accesul Chinei la datele legate de ADN-ul americanilor, în principal din trei motive. În cadrul interviului „60 minutes”, Evanina a vorbit despre scenariul foarte probabil în urma căruia companiile din China vor putea să țintească precis indivizi din America cu soluții de sănătate preventive, pe baza ADN-ului lor. Evanina a ridicat întrebarea: „Vrem ca o altă națiune să ne pună la pământ în mod sistematic serviciile medicale? Ca națiune, suntem în regulă cu acest lucru?”
A doua îngrijorare este că China ar putea folosi ADN-ul pentru a urmări și ataca persoane specifice din America. După cum se scrie în raportul USCC, „China ar putea transforma într-o țintă anumite vulnerabilități pe care le are cineva, descoperite în urma datelor genetice sau datelor personale de sănătate. Indivizii țintă care ar fi victimele acestor atacuri, cel mai probabil ar fi persoane strategic alese, cum ar fi diplomați, politicieni, oficiali federali de nivel înalt, sau cei din conducerea militară.” Dr. Steven Mosher, președintele Institutului de Cercetare a Populației (PRI), crede că acest scenariu este foarte probabil.
A treia îngrijorare este că China ar putea dezvolta arme biologice prin care să facă rău persoanelor care nu sunt de origine asiatică. Mosher descrie cum ar arăta acest scenariu, într-un articol intitulat „Ce va face China cu ADN-ul tău.” Acesta a scris următoarele: „Știm că genomul asiatic este distinct în multe moduri, din punct de vedere genetic, de cel caucazian și african... Ar fi posibil să construiești o versiune foarte virulentă de, să spunem, vărsat de vânt, care ar fi ușor transmisibil, fatal pentru celelalte rase, dar în fața căruia chinezii să se bucure de o imunitate naturală? ... Având în vedere capacitatea noastră prezentă de a manipula genomul, dacă o astfel de armă biologică ar putea fi concepută, s-ar putea, având destul timp și resurse, chiar să fie creată.” În timp ce acest lucru ar fi o adevărată provocare, și până acum nu există nicio dovadă că o astfel de armă ar putea fi creată, consecințele sunt mult prea înfricoșătoare pentru a fi ignorate.
Recoltarea de Organe
Însă există un motiv de care cei mai mulți americani nu sunt nici măcar conștienți. Acesta ar putea fi cel mai puternic și cel mai practic motiv pentru care China adună date despre ADN, atât din China cât și din afara ei. Acest motiv este mult prea malefic pentru a fi crezut, însă acest fenomen se întâmplă de mai bine de două decenii și încă are loc și în prezent: recoltarea forțată de organe.
China a început să-și construiască baza de date de ADN în 1999, prin intermediul sistemului său de securitate publică, când Comitetul Național de Statistică a aprobat proiectul „Baza de date de ADN a criminalilor”, condus de Institutul de Medicină Legală și Știință al Ministerului Justiției din China. Momentul a coincis cu începerea persecuției pe scară largă a practicanților Falun Gong, și recoltarea forțată de organe de la practicanți închiși și alți prizonieri de conștiință.
De atunci, China și-a mărit baza de date de ADN cu o viteză foarte mare. În 2003, biroul de securitate publică avea mai puțin de 100.000 de înscriși. În jurul anului 2017, China a lansat o campanie la nivel național pentru a impune colectarea de ADN. În 2018, baza de date a ajuns la 70 de milioane de profiluri. Pentru a privi lucrurile dintr-o altă perspectivă, baza de data cu ADN a FBI, CODIS, a fost creată cu un deceniu mai devreme decât cea a Chinei. În septembrie 2020, aceasta avea doar în jur de 19 milioane de profiluri.
În ziua de astăzi, o bază de date națională de ADN nu este un lucru neobișnuit în lume, și este de obicei folosită în scopuri legale și etice. Dar precum internetul, telecom și alte tehnologii, o astfel de bază de date poate fi folosită în scopuri negative dacă pică în mâinile PCC.
În „Raportul din 2019 privind libertatea religioasă internațională: China”, Biroul pentru Libertatea Religioasă Internațională din SUA a citat ONG-ul „Coaliția Internațională pentru a pune Capăt Abuzului de Transplant”, concluzionând că „recoltarea forțată de organe a avut loc timp de ani de zile în China la o scară semnificativă, și că practicanții Falun Gong au fost una dintre, cel mai probabil principala, sursă de organe.”
Conform mai multor surse, transplanturile de organe din China au început să atingă niveluri foarte înalte în jurul anului 2000. Astăzi, China efectuează în jur de 10.000 de transplanturi de organe în fiecare an, majoritatea fiind organe vitale precum ficat și plămâni. Timpul mediu de așteptare pentru un organ vital este între 2 și 4 săptămâni, comparativ cu 3 ani, cât se așteaptă în restul lumii. (pdf)
Faptul că baza de data de ADN a Chinei a crescut în același timp cu numărul de transplanturi de organe, nu este o coincidență. De când a început persecuția Falun Gong în 1999, milioane de practicanți au fost închiși, unii în lagăre de muncă, alții în închisori. În timp ce erau închiși, practicanții Falun Gong erau în mod constant forțați să facă teste de sânge pentru a li se verifica sănătatea organelor, în timp ce alți deținuți erau lăsați în pace.
Mai mult decât atât, colectarea de ADN nu se rezumă doar la închisori și lagăre de muncă. Au fost multe relatări în care poliția venea în casele practicanților Falun Gong și efectua recoltări forțate de ADN. Într-un raport, trei persoane din cadrul securității publice au intrat cu forța în casa doamnei Yang Guizhu, în vârstă de 64 de ani, care a lucrat pentru guvern, dar care a ieșit la pensie în 2013, și au cerut să ia o mostră din sângele doamnei Yang pentru teste ADN. După ce aceasta a refuzat, cei trei bărbați au ținut-o la pământ cu forța pe doamna Yang în timp ce i-au luat din sânge.
Minorități etnice precum uigurii au fost de asemenea victime ale recoltării forțate de organe. În ultimii ani, autoritățile din China au lansat mai multe campanii prin care să le colecteze ADN-ul, împreună cu alte date biometrice. Din 2016, fiecare rezident din Xinjiang, între 12 și 65 de ani, a fost forțat să ofere mostre de ADN și să treacă prin teste de scanare de retină și luare de amprente în fiecare an, în numele „examinărilor medicale gratuite,” conform Xinhua.
De la sfârșitul anului 2019, China a început să adune ADN de la cetățenii de rând. Poliția și-a făcut apariția în școli, sate, și reședințe pentru a colecta mostre de ADN și alte informații, iar oamenii nu aveau opțiunea de a refuza.
Astfel de practici sunt de neconceput în alte țări, iar în unele locuri a fost interzisă înregistrarea permanentă a datelor legate de ADN, cu scopul de a proteja intimitatea cetățenilor și drepturile omului.
Deși lumea nu știe încă tot ceea ce a făcut sau plănuiește să facă China cu baza sa de date masivă de ADN pe care a construit-o în ultimele două decenii, este un lucru sigur că nu ar trebui să avem încredere să acordăm informațiile noastre personale unui regim autoritar care a săvârșit numeroase crime împotriva umanității.
Astăzi nu există nicio restricție impusă companiilor de biotehnologie din SUA de a vinde tehnologie sau echipamente Chinei, nici pentru testarea ADN-ului american în China, nici pentru transferul de informații genetice din SUA către acea țară. Cred că a sosit momentul ca guvernul SUA și legiuitorii să urmărească cu o atenție mai mare această problemă, înainte să se facă și mai mult rău.
Printre surse: theepochtimes.com